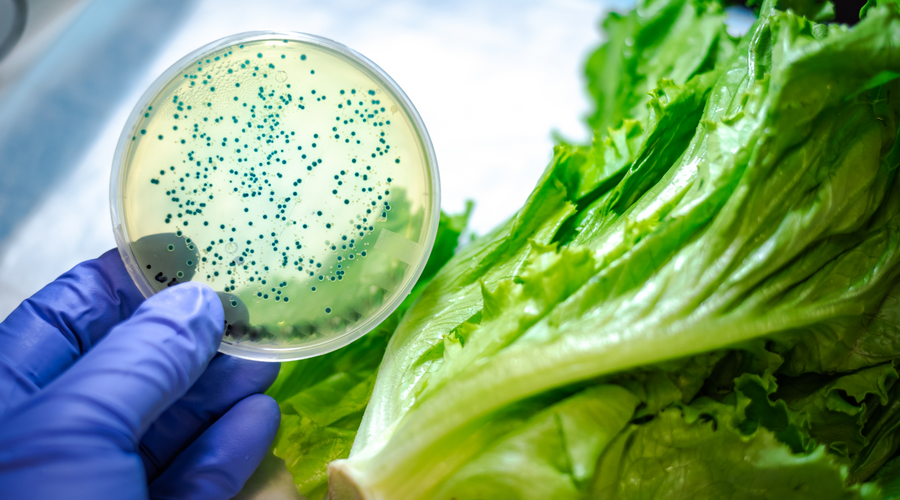

E. coli
The 2022 Food Recall Guide
What is a Food Recall?
In the food industry, countless things can go wrong. A food recall is when a company or indivi...
What is an E. coli Infection?
Escherichia coli, better known as E. coli, is probably best known as the bacteria behind countless food recalls (and...